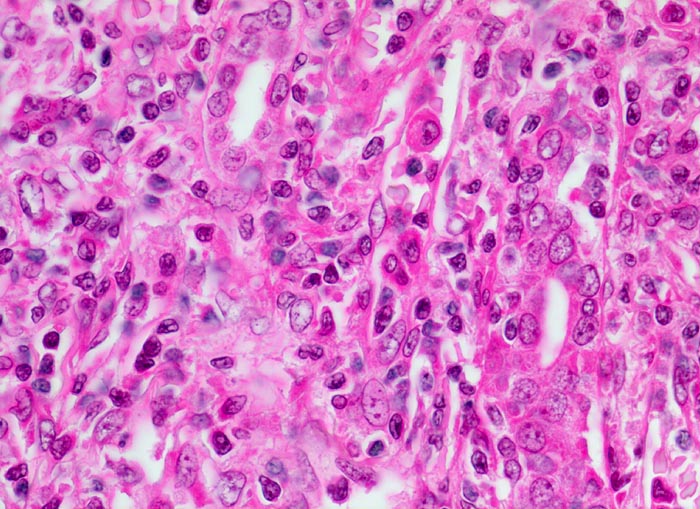

PathoPic – image database / PathoPic ID 4807 - akute Transplantatverwerfung: Tubulitis
de
Diagnose
akute Transplantatverwerfung: Tubulitis
Diagnose Gruppe
Systemerkrankung/Immunpathologie
Topographie
Niere
Topographie Gruppe
Niere, Harnwege
Beschreibung
Klinik
Leichennierentransplantation wegen dialysepflichtiger Niereninsuffizienz bei diabetischer Nephropathie. 5 Wochen nach Transplantation bemerkte der Patient ein Nachlassen der Urinausscheidung mit Gewichtsanstieg und Spannungsgefühl im Bereich des Transplantates. Trotz sofortiger Steigerung der immunsuppressiven Therapie kam es zum Transplantatversagen.
Kommentar
Das Bild entspricht einer behandlungsbedürftigen aggressiven zellulären akuten interstitiellen Abstossung.
Bilder Typ
Histologie
Vergrösserung
630
Alter
58
Geschlecht
männlich
Datum
Ersteintrag: 06.10.2002
Update: 16.07.2003